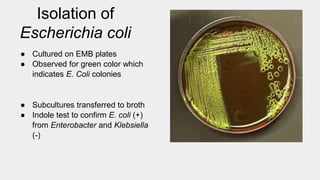

Coliscan® MF Colony Color Guide
Por um escritor misterioso
Last updated 21 março 2025

A guide to marker coloration for the Coliscan Membrane Filtration Kit.

Easygel - Akvopedia
0733-9372(2009)135:5(372)/asset/fe58ef95-b865-4df4-98de-456d269f42c3/assets/images/large/1.jpg)
Biphasic Decay Kinetics of Fecal Bacteria in Surface Water Not a Density Effect, Journal of Environmental Engineering

PDF) An evaluation of the effectiveness of the Gunderboom®in protecting waters from bacteria
Biol 400 independent project presentation

The Coliform Kind: E. coli and Its “Cousins”
Sold in sets of 10 tests, 1 set = 10 tests (test = 1 medium bottle, 1 regular treated petri dish), Discounted to $34.43 per set for orders of 10 or

Coliscan® Easygel® #25001
Test water, such as puddles and fountain water, and test surfaces of objects, such as desks and money) for bacteria.

Introductory Kit #INK20

quot;Significance of Methods and Sample Volumes for E. coli and Total

R-CARD® E. coli + Coliforms Water Testing Kit - Rapid Water Test – Roth Bioscience, LLC

Phylogenetic Identification of Colonies in Biofilter Outflow.

Full article: Illicit discharge detection and elimination: Low cost options for source identification and trackdown in stormwater systems

E. coli concentration in inflow and outflow from Stropharia

Measurement of Small Molecule Accumulation into Diderm Bacteria
Recomendado para você
-
HOW TO: Submit Cards for Grading to CGC in 2023 - Secret to GEM21 março 2025
-
78.jpg - Other Themes - CGC Comic Book Collectors Chat Boards21 março 2025
-
ProSense G25-SL100-4CB Mechanical Pressure Gauge - IMS Supply21 março 2025
-
CAPTAIN MARVEL #2 CGC 9.0 WHITE PAGES21 março 2025
-
Solved Асс UUG AGA UUA AGG AGU GCA CGA CCA UCA ACA GUA GCC21 março 2025
-
CGC Announces In-House Private Signing with Legendary Comic Writer21 março 2025
-
Maquinas 10 by Grupo Cultivar - Issuu21 março 2025
-
Small Green Painted Wooden Stool21 março 2025
-
2020 BEE BALM - Youth Short Sleeve T-shirt – MOFGA's Online21 março 2025
-
Buy Top Tunes for Flute Online at $8.99 - Flute World21 março 2025
você pode gostar
-
Stand Pop - Acrylic stand - The Eminence in Shadow / Alpha (Kage no Jitsuryokusha ni Naritakute!) (陰の実力者になりたくて! 東西イラスト アクリルフィギュア アルファ(C101))21 março 2025
-
Camiseta Oakley Super Casual Graphic - Camiseta Oakley Super Casual Graphic - Oakley21 março 2025
-
5 of the Best N64 Emulators - Make Tech Easier21 março 2025
-
At risk to be killed Wednesday 12/6/23 12:30pm CST At Animal Care Serv21 março 2025
-
RobloxPaperFolds (Closed for now 10/10) on X: Thank you guys for 55 Followers! Thank you for all the support. So to celebrate 55 followers, I made the floppa family. Btw I'm going21 março 2025
-
Jounin|Pesquisa do TikTok21 março 2025
-
IssacNewton 00-00/00-00 on X: @Alyssa96018841 @CalebRBX Idk man, I Took A Screenshot pretty easily / X21 março 2025
-
Dragon Ball Z Manga of 3 Volumes in 1 Omnibus book Vol. 121 março 2025
-
Decoração Peças De Xadrez Preto Rei E Cavalo Grande Luxo21 março 2025
-
À frente de Copa do Mundo, jogo da Série D registra segundo maior21 março 2025